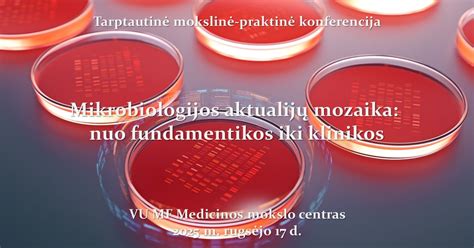
Mokslinė mikroskopinė grybelių nuotrauka

Daktarin yra vaistas, kurio veiklioji medžiaga yra mikonazolas, skirtas gydyti ir profilaktikai naudoti grybelių, įskaitant mielinius grybus (pavyzdžiui, Candida albicans), sukeltas infekcines ligas. Šis vaistas efektyviai veikia burnos ertmės, ryklės, stemplės, skrandžio ir žarnyno gleivinės infekcijas. Daktarin veikia naikindamas grybelių ląstelių sienelės svarbiausią komponentą - ergosterolį, taip sutrikdydamas grybelių gyvybines funkcijas ir stabdydamas jų dauginimąsi.
Kaip Daktarin veikia?
Mikonazolas, Daktarin veiklioji medžiaga, priklauso azolų grupės antimikotikams. Jis veikia grybelių ląstelės viduje, stabdydamas fermento lanosterolio 14α-demetilazės aktyvumą. Šis fermentas yra būtinas ergosterolio - pagrindinio grybelių ląstelės membranos komponento - sintezei. Be ergosterolio, grybelių ląstelės membrana tampa pralaidesnė, praranda savo struktūrinį vientisumą ir funkcijas, o tai galiausiai lemia grybelio žūtį. Be to, mikonazolas pasižymi antibakteriniu poveikiu prieš kai kuriuos Gram-teigiamus mikroorganizmus, todėl gali būti efektyvus gydant infekcijas, komplikuotas antrine bakterine flora.
Daktarin formos ir jų panaudojimas
Daktarin rinkoje siūlomas įvairiomis formomis, pritaikytomis skirtingoms gydymo reikmėms:
- Daktarin valgomasis gelis: Skirtas burnos ertmės, ryklės, stemplės, skrandžio ir žarnyno grybelinėms infekcijoms gydyti. Jo lipni konsistencija užtikrina ilgalaikį kontaktą su gleivine, leidžiant veikliajai medžiagai efektyviai veikti pažeistose vietose.
- Daktarin dermatologinė kremas: Naudojamas odos ir nagų grybelinėms infekcijoms gydyti, kurias sukelia dermatofitai ar Candida. Ši forma ypač tinkama drėgnoms odos pažeidimo vietoms.
- Daktarin dermatologinė polveris: Taip pat skirtas odos grybelinėms infekcijoms, ypač esant drėgmei. Polveris padeda palaikyti pažeistą vietą sausą ir apsaugo nuo tolesnio grybelio plitimo.
- Daktarin dermatologinė tirpalas: Dažniausiai naudojamas nagų grybelinėms infekcijoms gydyti. Tirpalas formuojamas plėvelę ant nago, taip užtikrinant ilgalaikį poveikį.
- Daktarin dermatologinis purškalas (polveris): Patogi forma greitam ir lengvam pažeistų odos plotų apdorojimui, ypač sunkiai pasiekiamose vietose.
Kiekviena forma turi specifines vartojimo rekomendacijas, kurios priklauso nuo infekcijos tipo, lokalizacijos ir paciento amžiaus.
Vartojimo instrukcijos ir dozavimas
Daktarin valgomasis gelis:
- Suaugusiems ir vyresniems nei 2 metų vaikams: Rekomenduojama vartoti po pusę 5 ml matavimo šaukšto (2,5 ml) gelio keturis kartus per parą po valgio. Gelio nereikėtų nuryti iš karto; patariama jį burnoje laikyti kuo ilgiau, kad užtikrintumėte ilgalaikį kontaktą su gleivine.
- Kūdikiams ir jaunesniems nei 2 metų vaikams (nuo 4-6 mėnesių): Rekomenduojama vartoti po ketvirtadalį 5 ml matavimo šaukšto (1,25 ml) gelio keturis kartus per parą po valgio. Kiekvieną dozę reikia padalinti į kelias dalis, siekiant užtikrinti, kad vaisto patektų į visas pažeistas burnos vietas. Ypač svarbu būti atsargiems, kad vaikas neuždustų - gelio negalima iš karto dėti į burną, jį reikia palaipsniui nuryti.
- Gydymo trukmė: Gydymą Daktarin geliu rekomenduojama tęsti dar mažiausiai savaitę po to, kai išnyksta ligos simptomai, siekiant užtikrinti visiško pasveikimo.
- Dantų protezai: Jei naudojami dantų protezai, juos nakčiai reikėtų išimti ir išvalyti su geliu, kad būtų apsaugoti nuo infekcijos.
Daktarin dermatologinės formos (kremas, polveris, tirpalas, purškalas):
- Bendrosios rekomendacijos: Prieš tepant vaistą, pažeistą vietą reikia kruopščiai nuplauti ir gerai nusausinti. Gydyti reikia ne tik pažeistą plotą, bet ir šiek tiek aplink jį. Po kiekvienos procedūros būtina kruopščiai nusiplauti rankas, kad būtų išvengta infekcijos plitimo į kitas kūno vietas ar kitiems žmonėms.
- Odos infekcijos: Gydymas turėtų būti tęsiamas bent savaitę po simptomų išnykimo ir gali trukti nuo 2 iki 6 savaičių, priklausomai nuo infekcijos tipo ir ploto. Polveris ir purškalas yra ypač tinkami drėgnoms žaizdoms. Kremas tepamas plonu sluoksniu ant pažeistos vietos ir įtrinamas iki visiško susigėrimo.
- Nagų infekcijos: Nagus reikia kirpti kuo trumpiau. Gydymą tęsti reikia net ir po pažeisto nago nukritimo, kol visiškai ataugs naujas nagas ir pažeidimas bus visiškai išgydytas (tai gali užtrukti iki 3 mėnesių). Kartais gali prireikti papildomo gydymo. Tirpalas tepamas šepetėliu ant nago ir aplink jį, leidus išdžiūti. Prieš kitą aplikaciją nagą reikia nuvalyti acetonu.
Svarbios saugumo priemonės ir įspėjimai
- Individualumas: Šis vaistas skirtas tik Jums, todėl negalima jo duoti kitiems žmonėms.
- Alerginės reakcijos: Daktarin gali sukelti sunkias alergines reakcijas. Žinokite alerginės reakcijos požymius (pvz., odos išbėrimas, niežulys, veido ar gerklės patinimas, kvėpavimo pasunkėjimas) ir nedelsdami kreipkitės į gydytoją, jei jie pasireiškia.
- Sąveika su kitais vaistais: Prieš pradedant vartoti Daktarin, būtinai pasakykite gydytojui arba vaistininkui, jei vartojate kitų vaistų, ypač:
- Vaistų ŽIV infekcijai gydyti (pvz., sakvinaviro).
- Vaistų, skirtų po organų persodinimo (pvz., ciklosporinas, takrolimuzas, rapamicinas).
- Geriamųjų antikoaguliantų (pvz., varfarino) - gali sustiprėti jų poveikis, todėl reikalinga nuolatinė kontrolė.
- Kai kurių hipoglikeminių vaistų (pvz., sulfonilkarbamido darinių) ir fenitoino - gali sustiprėti jų poveikis.
- Kai kurių vaistų nuo alergijos (pvz., terfenadino, astemizolo, cisapride, mizolastino).
- Kai kurių vaistų, vartojamų širdies ritmui reguliuoti (pvz., chinidino, bepridilio).
- Kai kurių vaistų, vartojamų cholesterolio kiekiui mažinti (pvz., simvastatinas, lovastatinas).
- Kai kurių vaistų, vartojamų migrenai gydyti (pvz., ergotamino dariniai).
- Kai kurių vaistų, vartojamų nerimui ar miego sutrikimams gydyti (pvz., triazolamas, geriamasis midazolamas).
- Nėštumas ir žindymas: Nors Daktarin per odą ar gleivinę rezorbuojasi minimaliai, nėštumo metu, ypač pirmąjį trimestrą, Daktarin turėtų būti vartojamas tik gydytojo nuožiūra, jei nauda viršija galimą riziką. Žindymo laikotarpiu taip pat patariama būti atsargiems.
- Vaikų gydymas: Būkite ypač atsargūs gydydami kūdikius ir mažus vaikus, kadangi lipnus gelis gali sukelti užspringimo pavojų. Dozę reikia dalinti ir duoti palaipsniui.
- Sąveika su latekso gaminiais: Daktarin kremai ir tirpalai gali pažeisti latekso gaminius, tokius kaip prezervatyvai ar diafragmos, todėl jų kartu vartoti nerekomenduojama.
Pieninio sąkandžio burnos ertmės priežiūra
Galimas šalutinis poveikis
Nors Daktarin paprastai gerai toleruojamas, gali pasireikšti šalutinis poveikis:
- Dažni (gali pasireikšti ne daugiau kaip 1 iš 10 žmonių):
- Odos dirginimas, deginimo pojūtis, niežulys, paraudimas ar kitos alerginės reakcijos, ypač vartojant dermatologines formas.
- Burnos ertmės gleivinės dirginimas, deginimo pojūtis, skonio sutrikimai (vartojant gelį).
- Nedažni (gali pasireikšti ne daugiau kaip 1 iš 100 žmonių):
- Pykinimas, vėmimas, viduriavimas (ypač vartojant dideles dozes ar ilgai).
- Reti (gali pasireikšti ne daugiau kaip 1 iš 1000 žmonių):
- Kepenų uždegimas (hepatitas), kuris gali pasireikšti apetito sumažėjimu, pykinimu, vėmimu, nuovargiu, pilvo skausmu, gelta, tamsiu šlapimu ir šviesiomis išmatomis. Tokiu atveju nedelsiant nutraukite vaisto vartojimą ir kreipkitės į gydytoją.
- Labai reti (gali pasireikšti ne daugiau kaip 1 iš 10 000 žmonių):
- Sunkios alerginės reakcijos, įskaitant anafilaksiją, angioedemą (veido, lūpų, liežuvio ar gerklės patinimas), dilgėlinę, sunkų odos išbėrimą (pvz., Stivenso-Džonsono sindromas, toksinė epidermio nekrolizė).
- Padidėjęs kepenų fermentų aktyvumas.
Jeigu pasireiškė šalutinis poveikis, įskaitant šiame lapelyje nenurodytą, pasakykite gydytojui arba vaistininkui.
Perdozavimas
- Valgomojo gelio atveju: Atsitiktinai pavartojus didelį kiekį gelio gali pasireikšti vėmimas ir viduriavimas. Tokiu atveju būtina kreiptis į gydytoją arba skubiosios pagalbos tarnybą. Gali prireikti skrandžio plovimo.
- Dermatologinių formų atveju: Per didelis dermatologinių formų vartojimas gali sukelti odos sudirginimą, kuris paprastai praeina nutraukus gydymą. Atsitiktinai prariidus didelį kiekį dermatologinių preparatų, reikia naudoti palaikomąją terapiją.
Laikymas ir tinkamumo laikas
- Vaistą laikyti ne aukštesnėje kaip 25°C temperatūroje.
- Laikyti vaikams nepasiekiamoje ir nepastebimoje vietoje.
- Nenaudokite vaisto pasibaigus tinkamumo laikui, nurodytam ant pakuotės po „Tinka iki“ (EXP).
Nereikalingų vaistų šalinimas
Vaistų negalima išmesti į kanalizaciją arba su buitinėmis atliekomis. Kaip išmesti nereikalingus vaistus, klauskite vaistininko.
Išvada
Daktarin yra veiksmingas vaistas, skirtas įvairioms grybelinėms infekcijoms gydyti. Svarbu atidžiai perskaityti ir laikytis vaistinio preparato informacinio lapelio nurodymų, konsultuotis su gydytoju ar vaistininku dėl tinkamiausios formos, dozavimo ir gydymo trukmės. Būkite atidūs dėl galimo šalutinio poveikio ir sąveikos su kitais vaistais, kad užtikrintumėte saugų ir efektyvų gydymą.